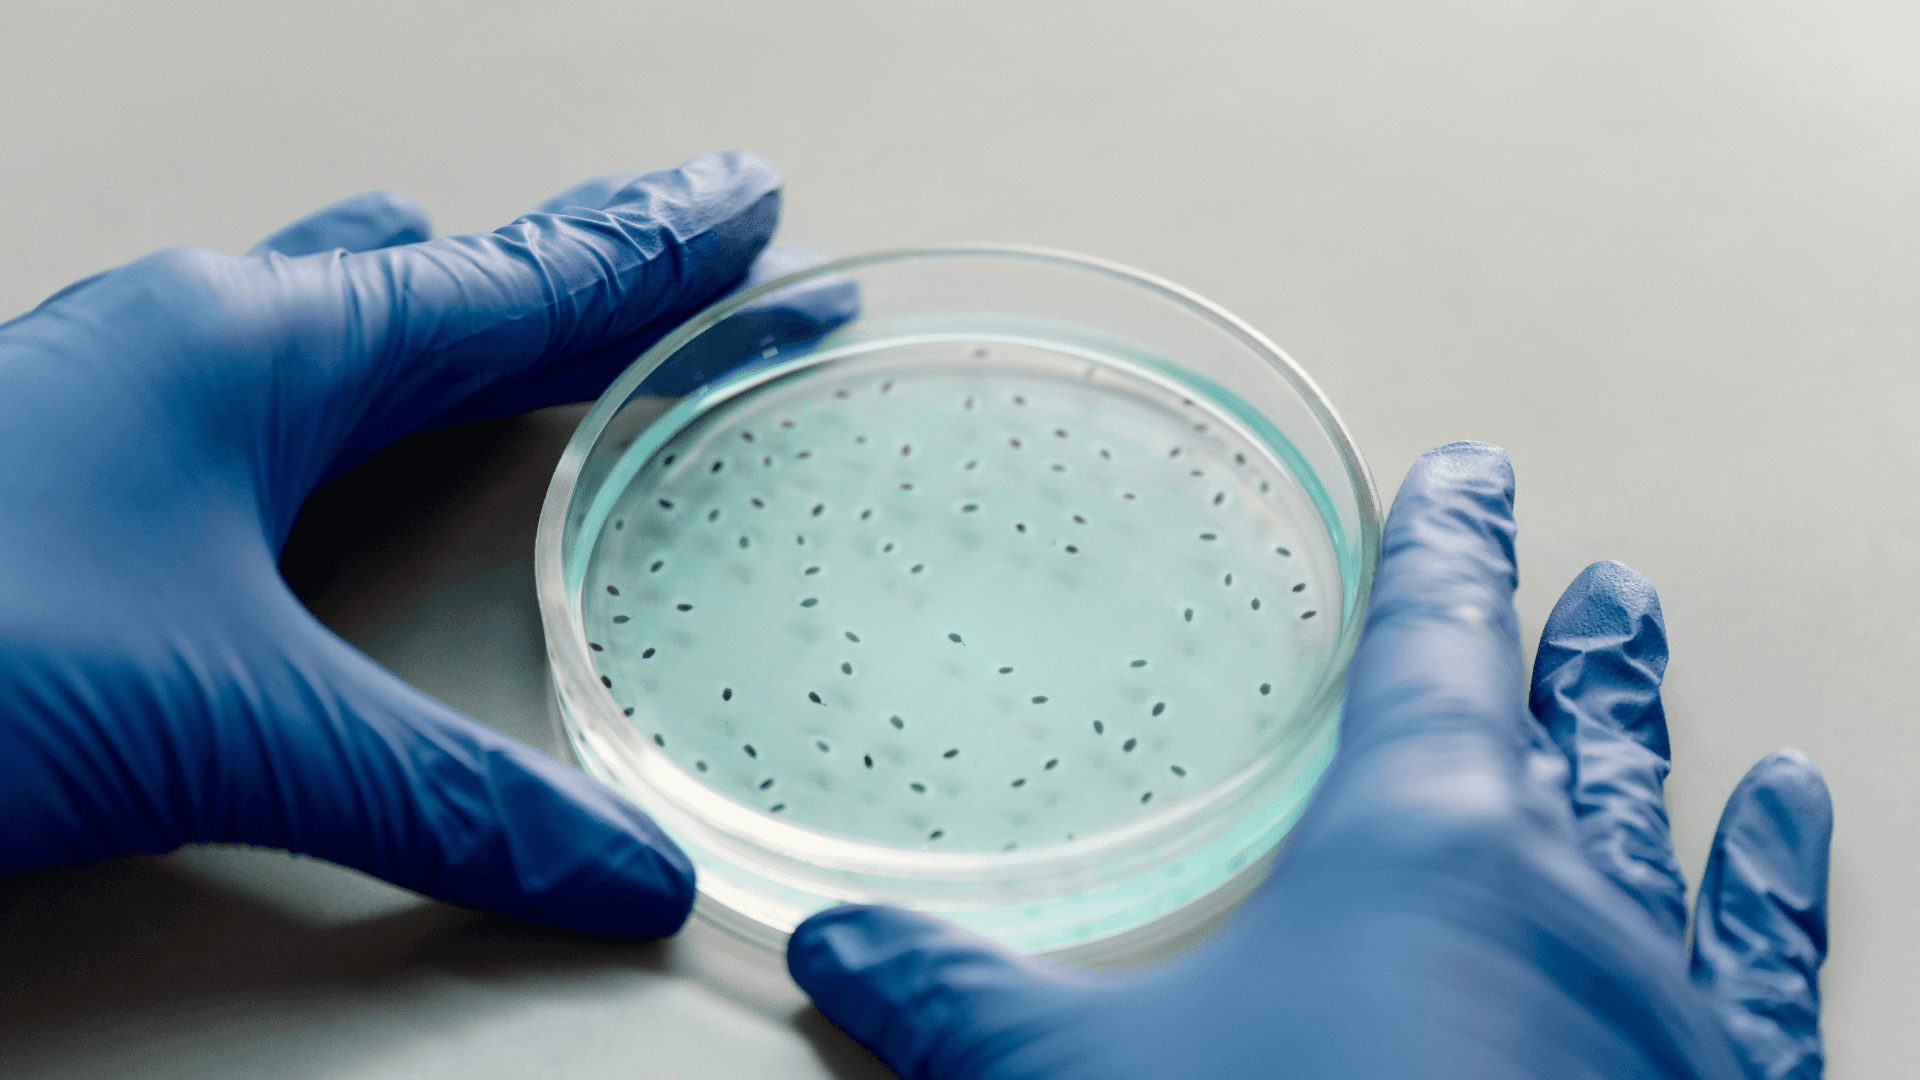

OUR SCIENCE
We don't sell isolated inputs. We engineer a system where each pillar makes the next one more effective — compounding protection every season.
FEED
Build and rebuild the foundation.
Everything starts with soil biology. Decades of chemical fertilizer use have depleted the microbial life that makes soil work — organisms that cycle nutrients, retain water, and suppress disease naturally.
Our Feed pillar restores this foundation through Terra™, a microbially-rich vermicompost that delivers organic carbon, beneficial microorganisms, and the substrate that sustains all downstream biological activity.
Feed doesn't replace fertilizer. It makes fertilizer work better — and creates conditions where biological defense can take root.

PROTECT
Close the loop. Shield against risk.
Most biocontrol products fail because the microbes die after application — they have no food source. Our Protect pillar solves this structurally.
We design microbial consortia — multi-strain combinations that suppress pathogens through multiple mechanisms simultaneously: mycoparasitism, antibiosis, competitive exclusion, and induced systemic resistance.
These consortia are delivered through our vermicompost carrier. The Feed pillar literally feeds the Protect pillar. No standalone inoculant can replicate this.

DETECT
Make the invisible risk visible.
By the time a plant shows disease symptoms, significant damage has already occurred. Farmers make decisions with no visibility into their soil.
Our Detect pillar closes this gap with low-cost molecular diagnostics — PCR-based pathogen detection that tells farmers what's in their soil before crisis.
etect completes the loop: monitors pathogen loads, guides when to reapply, and tells us which consortium to recommend next.
THE COMPOUNDING LOOP
Feed enables Protect.
Protect justifies Feed.
Detect guides both.
Self-sustaining, disease-resistant systems
that compound value every season.
BIOLOGICAL INTELLIGENCE ENGINE
TanaSense
The machine learning platform behind our biological design decisions.
TanaSense evaluates thousands of possible microbial strain combinations and predicts the optimal consortium for any crop-disease or crop-nutrition target.
It operates in two modes: Protect mode identifies the best consortium for pathogen suppression across 8 pathosystems. Feed mode optimizes for agronomic outcomes across 9 targets.
Every lab result feeds back. The system gets smarter every season — building proprietary biological intelligence over time.
Design
Predict optimal consortium
Build
Prepare on carrier
Test
Deploy & measure
Learn
Feed back, improve
Now · V1.0
Literature-Trained
200+ DOI datapoints across all pathosystems.
End of Year · V1.5
Proprietary Data
50+ proprietary bioassays. Predictions diverge from literature.
Next Year · V2.0
Context-Aware
Soil type, season, pathogen load. Prescribes per hectare.

Write to us →
© 2026 PT Tana Makmur Lestari
info@tana-lab.com · Tangerang, Indonesia
